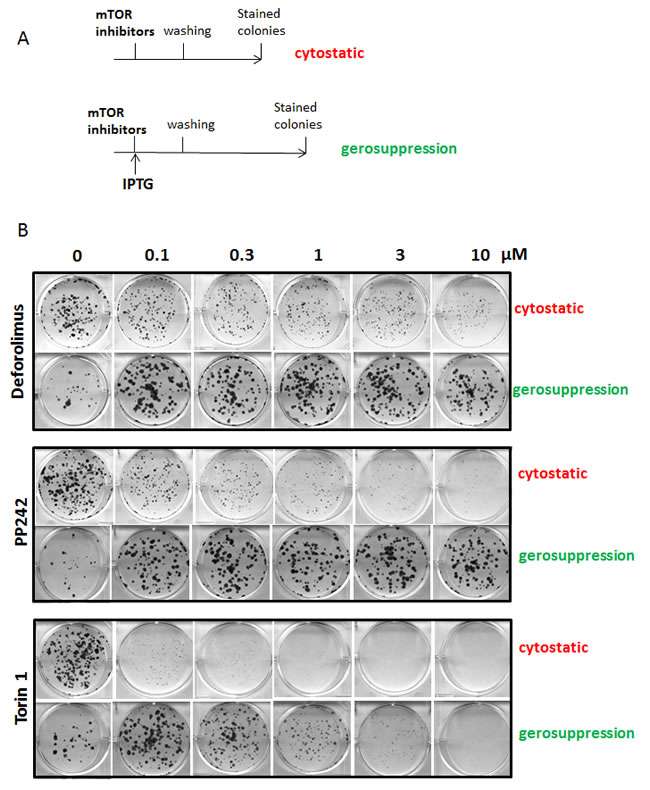
fig1

Introduction
Aging is driven by conservative genetic pathways [1-21]. These pathways converge at TOR (target of rapamycin) [22-26]. Allosteric mTOR inhibitors known as rapalogs such as rapamycin (Sirolimus), everolimus, deforolimus and temsirolimus are available in the clinic [27-33].
Rapamycin and other rapalogs inhibit some, but not all, mTOR functions [34-43]. Rapalogs bind FKBP12 and this complex in turn inhibits mTOR complex 1 (mTORC1). In most conditions, rapamycin does not inhibit mTOR complex 2 (mTORC2). Inhibition of phosphorylation of mTORC1 substrates by rapamycin is concentration-dependent [41]. At clinically-relevant concentrations, rapamycin does not inhibit phosphorylation of 4EBP1 at T37/46, while inhibiting S6K/ S6 pathway [34-44]. In contrast, direct inhibitors of the TOR kinase (non-rapalogs) abrogate all activities of mTORC1 and mTORC2 [39, 45-48]. These ATP-competitive inhibitors of the TOR kinase are not selective and at higher concentrations inhibit PI3K, ATM and some other kinases.
It is difficult to predict the outcome of life-long administration of dual mTOR inhibitors in animals. On one hand, they inhibit both rapamycin-sensitive and -insensitive functions of mTOR and thus might extend life span extensively. Yet, the role of rapamycin-insensitive functions in aging is unknown. Furthermore, potential toxicity due to lack of selectivity toward TOR may preclude antiaging effects. Fortunately, a simple cellular model is available to investigate anti-aging activity in cell culture. In proliferating cells, mTOR is active and drives cellular growth. When the cell cycle is forcefully arrested, but mTOR is still active (as in proliferating cells), then mTOR drives “senescence” [49, 50].
In other words, mTOR drives conversion from reversible cell cycle arrest to senescence (geroconversion) and rapamycin suppresses or decelerates geroconversion [51-79].
Senescent cells cannot restart proliferation (re-proliferation), even when the arrest is lifted and cells re-enter the cell cycle. In the presence of active mTOR, p21- or p16-arrested cells lose their re-proliferative potential (RP). In the presence of rapamycin [54, 55, 62] and everolimus [61], cells maintain RP during cell cycle arrest and can re-proliferate, when the arrest is lifted. Also, rapalogs moderately suppress cellular hypertrophy and beta-Gal-positive senescent morphology. Here we tested whether non-rapalog mTOR inhibitors such as Torin 1 and PP242 can suppress geroconversion.
Results
mTOR inhibitors suppress geroconversion
We compared gerosuppressive and anti-proliferative (cytostatic) effects of dual mTOR inhibitors, Torin 1 and PP242 (Fig. 1A). We also tested deforolimus, a rapalog also known as ridaforolimus. To measure cytostatic effects, proliferating HT-p21 cells were treated with these inhibitors (Fig. 1). After a 3-day treatment, drugs were washed out and cells were incubated in fresh medium for another 3-6 days. Colonies were stained with Crystal Violet. TOR inhibitors decreased size of colonies but not their number. This is consistent with reversible inhibition of proliferation in the presence of inhibitors (Fig. 1). Cells retained their re-proliferative potential and resumed proliferation when the inhibitors were removed. Therefore, the number of colonies remained the same as in control but their size became progressively smaller with increasing concentrations of inhibitors (Fig.1, see “cytostatic” panels).
To investigate effects of the drugs on geroconversion, we induced ectopic p21 in HT-p21 cells by treating them with IPTG [62, 80, 81]. These cells undergo senescence when p21 is turned on by IPTG and lose their re-proliferative potential (RP). When IPTG is washed out, the senescent cells can re-enter the cell cycle but cannot proliferate [63].
Suppression of geroconversion was evaluated by the ability of IPTG-treated HT-p21 cells to resume proliferation after IPTG was removed (Fig. 1, gerosuppression). Treatment with IPTG alone decreased the number of colonies, (Fig. 1B; no drug). This is consistent with irreversible senescence in most IPTG-treated cells, so only a few cells were quiescent and retained RP. Treatment of IPTG-arrested cells with deforolimus, Torin 1 or PP242 increased the number of colonies. These colony-forming cells were in quiescent state and retained potential to re-proliferate. Cells resumed proliferation once IPTG and drugs were removed. In summary, the effects of mTOR inhibitors on proliferation (cytostatic effect) and re-proliferative potential (gerosuppressive effect) were opposite. While decreasing the size of colonies in first case, mTOR inhibitors increased the number of colonies in second case (Fig. 1B).
At concentrations shown in Fig. 1B, gerosuppressive effect of Torin 1 was maximal at the lowest concentration shown (100 nM). At higher concentrations (> 300 nM), the gerosuppressive effect of Torin 1 was partially lower (Torin 1 partially canceled its gerosuppressive effect) and colonies became smaller. Therefore, we next titrated concentrations down (Fig. 2A). IPTG-arrested HT-p21 cells were treated with a range of concentrations from 1 nM to 3000 nM, according to experimental schema shown in Fig. 1A. Gerosuppressive effect of Torin 1 was shifted toward lower concentrations compared to that of PP242 (Fig. 2A). Minimal concentrations that suppressed geroconversion were 1 nM and 10 nM for Torin 1 and PP242, respectively. Maximum effects of Torin 1 and PP242 were observed at concentrations 30 nM and 300 nM, respectively, indicating that Torin 1 is overall 10 times more potent than PP242. Therefore, 10-fold lower concentrations of Torin 1 than PP242 could be used to achieve equipotent effect.
Figure 1: Cytostatic and gerosuppressive effects. A. Schema of experiment; B. Cytostatic and gerosupressive effects of deforolimus, Torin 1 and PP242 in HT-p21 cells. Cells were treated with serial dilutions of deforolimus, PP242 or Torin 1 as depicted in schema in (A). To determine cytostatic activity, cells were treated with drugs for 3 days, then drugs were washed out and cells were allowed to recover in drug-free medium. Colonies were stained after 5 days of regrowth. To investigate drug effects on geroconversion, HT-p21 cells were treated with IPTG in the presence of serial dilutions of the drugs. After 3-day treatment, drugs were washed out and colonies were allowed to form for 9 days, then stained and counted in triplicates. Data are mean ± SD.
Correlation between gerosuppression and mTOR inhibition
We next investigated inhibition of the mTOR pathway by Torin 1 and PP242. Consistent with gerosuppressive effects (Fig. 2A), Torin 1 inhibited phosphorylation of S6 kinase (target of mTORC1) and its downstream target phospho-S6 at concentrations 10 times lower than PP242 (Fig. 2B). The inhibition of the S6K/S6 axis corresponded to concentrations at which preservation of RP (gerosuppression) was observed. The S6K/S6 axis is a major target of rapamycin.
At higher concentrations, at which gerosuppression was already near-maximal, Torin 1 and PP242 exerted rapamycin-resistant effects: namely, inhibition of phosphorylation of 4EBP1 (T37/46) and Akt (S473). Equipotent concentrations were approximately 10 times higher for PP242 than for Torin 1.
Finally, like rapamycin, Torin 1 and PP242 did not decrease p21 levels, so they did not abrogate IPTG-induced arrest. At equipotent concentrations both mTOR inhibitors decreased cyclin D1, a marker of senescent hyper-mitogenic cell cycle arrest [63]. Hyper-elevated cyclin D1 is a common marker of senescent phenotype [63].

Figure 2: Gerosuppression and mTOR inhibition. A. Geroconversion. Torin 1 and PP242 were added to IPTG-treated HT-p21 cells, as shown in Figure 1A. Cells plated at low density were treated with IPTG in the presence of serial dilutions of inhibitors. After 3 days, IPTG and inhibitors were washed out and cells were incubated in drug-free medium. Then colonies were stained with Crystal Violet and counted. Data are mean number of colonies per a sector of a well ± SD. B. Immunoblot analysis. HT-p21 cells were treated with IPTG in combination with Torin 1 or PP242 for 24 h and lysed. Rapamycin (R) at 500 nM was included as additional control. Immunoblotting was performed with the indicated antibodies. Note: IPTG-induced p21 is highly expressed in all samples, confirming that the inhibitors do not interfere with p21 induction by IPTG and cell cycle arrest.
mTOR kinase inhibitors prevent senescent morphology
Treatment with IPTG resulted in a large flat cell morphology and beta-Gal-positivity (Fig. 3A). Enlarged cell size was due to hypertrophy as indicated by increased amount of protein per cell (Fig. 3B, compare control and IPTG). Torin 1 or PP242 prevented senescent morphology and decreased cell size. As it has been previously shown, rapamycin partially decreased beta-Gal staining. Rapamycin only partially prevented senescent morphology and hypertrophy (Fig. 3). Notably, Torin 1 and PP242 were far more potent in suppressing senescent morphology and hypertrophy, compared with rapamycin.

Figure 3: Torin 1 and PP242 prevent senescent morphology and hypertrophy in HT-p21 cells induced to senesce by IPTG. A. Cells were treated with IPTG (I) in the presence of Torin 1, PP242 or Rapamycin (R) for 4 days and stained for beta-Gal. Bar – 100 µm. B. Cells were treated with IPTG in combination with Torin 1 (100 nM), PP242 (1000 nM) or rapamycin (500 nM). After 3 days, cells were counted and lysed. Protein concentrations were measured. Data present mean ± SD of ng of protein per cell.
Dual inhibitors of TORC1/2 prevent etoposide- and doxorubicin-induced senescence in normal human fibroblasts WI38t
To investigate whether gerosuppressive activity of Torin 1 and PP242 is not cell-type specific, we next examined their effect on senescent morphology and RP in WI38t fibroblasts undergoing senescence by treatment with low concentrations of etoposide or doxorubicin. As shown in Fig. 4A, both etoposide and doxorubicin treatment caused large flat and beta-gal positive morphology in WI38t cells. In etoposide- and doxorubicin-treated cells, co-treatment with either Torin 1 or PP242 prevented senescent morphology. Furthermore, when WI38t cells were pre-treated with either senescing-drug (etoposide or doxorubicin) alone, most of the cells lost the ability to re-proliferate after drugs were removed. Co-treatment of cells with senescing-drugs and either Torin 1 or PP242 preserved RP after removal of the drugs. In other words, treatment of cells with etoposide in the presence of either Torin 1 or PP242 preserved some cells in reversible quiescence instead of irreversible senescence. mTOR inhibitors also prevented senescent morphology of SKBR3 cells undergoing senescence by treatment with PMA (Fig. 4C), a model of senescence described previously [82].

Figure 4: Torin 1 and PP242 suppress geroconversion in human WI38t fibroblasts and SkBr3 cells. A. WI38t cells were treated with either 1 µg/ml etoposide or 50 ng/ml doxorubicin in the absence or presence of 100 nM Torin 1 or 1 µM PP242 for 4 days and stained for beta-Gal. Bar – 100 µm. B. Cells were treated as in (A). After 4-day treatment, cells were extensively washed to remove the drugs and allowed to regrow in drug-free medium and counted after 3 weeks in culture. RP (re-proliferative potential) was calculated by dividing final cell numbers by initially-plated number of cells. Data present mean ±SD from triplicate wells. C. Effect of Torin 1 on senescent morphology of SKBR3 cells undergoing senescence induced by PMA. Cells were pre-treated with Torin 1 (100 nM) for 24 h before addition of 100 nM PMA. After 3-day treatment with PMA, drugs were washed out, cells were incubated in drug-free medium for another 3 days and stained for beta-gal. Bar – 100 µm.
Discussion
Rapamycin and other rapalogs are anti-inflammatory and anti-aging drugs [83, 84]. Rapamycin slows down aging, prevents age-related diseases and extends life span in all species tested, including mice [85-104].
On cellular level, rapamycin and other rapalogs inhibit geroconversion from cell cycle arrest to senescence [51, 50]. In the organism, geroconversion drives hyperfunctions, slowly causing age-related pathologies [22, 105-107]. Suppression of geroconversion (gerosuppression) by rapalogs is a surrogate of their anti-aging effects. Therefore, to evaluate whether dual mTOR inhibitors are potential anti-aging drugs, we investigated gerosuppression in cell culture.
Loss of re-proliferative potential (RP) is a quantitative marker of geroconversion. Non-senescent (quiescent) cells retain RP, meaning that they can re-start proliferation (re-proliferation), when arrest is reversed. In contrast, senescent cells lack RP. We found that in the presence of Torin 1 and PP242, arrested cells retained RP. Like rapalogs, these pan-mTOR inhibitors prevented loss of RP during cell cycle arrest caused by p21 and etoposide. Importantly, mTOR inhibitors suppressed geroconversion despite their intrinsic anti-proliferative effect (in proliferating cells).
The ability of mTOR inhibitors to preserve RP indicates that (at gerosuppressive concentrations) mTOR inhibitors are not harmful in any way; otherwise cells would not resume proliferation and would not form colonies. In fact, at high concentrations, the gerosuppressive effect, measured as preservation of RP, decreased and even disappeared.
Gerosuppression coincided with inhibition of the mTORC1/S6K/S6 axis. The maximal gerosuppression, as measured by RP, was similar for rapalogs and pan-mTOR inhibitors.
PP242 was 10 times less potent but it was also less cytostatic and inhibited mTORC1/S6K/S6 at 10-fold higher concentrations. We conclude that their effects are almost identical at equipotent concentrations. At high concentrations, Torin 1 and PP242 were more efficient than rapamycin in suppressing cellular hypertrophy and senescent morphology. This indicates that morphology and hypertrophy depend in part on rapamycin-insensitive functions of mTOR.
Rapamycin and other rapalogs have been safely used even in daily high doses for many years in patients [108-110], so their use as anti-aging drugs (intermittent schedules) is expected to be without significant side effects. Dual mTOR inhibitors have all activities of rapamycin plus other effects and therefore must have more side effects by definition. Still, our study indicates that, at low concentrations, they may be considered as potential anti-aging drugs because they can preserve re-proliferation, which would be impossible if the drugs were toxic, given the delicate mechanism of cellular division.
Still, mTOR inhibitors are cytostatic. Therefore, for their clinical development as anti-aging drugs, it would be important to determine balance between cytostatic vs gerosuppressive effects. mTOR inhibitors also vary in their affinity to mTORC1 and mTORC2 complexes, as well as by their off-target effects. Therefore, a larger variety of inhibitors should be further tested at a wider range of concentrations for their effects on cell proliferation vs geroconversion. Optimal gerosuppressive concentrations of various mTOR inhibitors should be selected (Oncoscience, 2015, in press).
Materials and Methods
Cell lines and reagents
HT-p21 cells, derived from HT1080 human fibrosarcoma cells, in which p21 expression can be turned on and off using IPTG (isopropyl-thio-galactosidase) were described [80, 81, 62]. HT-p21 cells were cultured in DMEM/10% FC2 serum (HyClone FetaClone II; HyClone Laboratories, Inc, Logan, UT), Immortalized WI38t human fibroblasts, described previously [111], and SKBR3, breast adenocarcinoma cell line (ATCC, Manassas, VA), were maintained in DMEM/10% FBS. Rapamycin was purchase from LC Laboratories (Woburn,MA). Torin 1 and PP242 were from Selleckchem (Houston, TX). Stock solutions were prepared in DMSO.
Re-proliferative potential (RP)
Cells were plated at low densities and treated with senescence-inducing agents as described in figure legends. After 3-4-day treatment drugs were washed out and cells were allowed to regrow in drug-free medium for a few days as indicated in figure legends. Colonies were stained with 1% Crystal Violet (Sigma-Aldrich) and counted.
Immunoblot analysis
Whole cell lysates were prepared using boiling lysis buffer (1%SDS, 10 mM Tris.HCl, pH 7.4). Equal amounts of proteins were separated on 10% or gradient polyacrylamide gels and transferred onto PVDF membranes [111]. Primary antibodies for the following proteins were used: rabbit antibodies for phospho-p70S6K(T389), phospho-pS6(S235/236), phospho-4EBP1(T37/46), phospho-AKT(S473), AKT and mouse antibody for S6 – from Cell Signaling Technology (Danvers, MA); mouse antibodies for cyclin D1 and p21 were from Santa Cruz Biotechnology (Paso Robles, CA) and BD Biosciences (San Jose, CA), respectively. Actin antibody was purchased from Sigma-Aldrich (St. Louis, MO).
Secondary anti-mouse and anti-rabbit antibodies were from Cell Signaling.
SA-β-Gal staining
β-gal staining was performed using Senescence-galactosidase staining kit (Cell Signaling Technology), according to manufacturer’s protocol. Cells were microphotographed under light microscope.
Author Contributions
MVB conceptualized the project, designed the experiments and wrote the manuscript. OL and ZD performed the experiments, reviewed the manuscript and gave their feedback. MVB oversaw the project.
FUNDING
Roswell Park Cancer Institute, Buffalo, NY 14203.
Conflicts of Interests
MVB is a consultant at Everon Biosciences, Inc.
Other authors have no conflicts to declare
References
1. Kenyon C, Chang J, Gensch E, Rudner A, Tabtiang R. A C. elegans mutant that lives twice as long as wild type. Nature. 1993: 461-464.
2. Kenyon C. The plasticity of aging: insights from long-lived mutants. Cell. 2005; 120: 449-460.
3. Vellai T, Takacs-Vellai K, Zhang Y, Kovacs AL, Orosz L, Muller F. Genetics: influence of TOR kinase on lifespan in C. elegans. Nature. 2003; 426: 620.
4. Kapahi P, Zid BM, Harper T, Koslover D, Sapin V, Benzer S. Regulation of lifespan in Drosophila by modulation of genes in the TOR signaling pathway. Curr Biol. 2004; 14: 885-890.
5. Kaeberlein M, Powers RWr, K.K. S, Westman EA, Hu D, Dang N, Kerr EO, Kirkland KT, Fields S, Kennedy BK. Regulation of yeast replicative life span by TOR and Sch9 in response to nutrients. Science. 2005; 310: 1193-1196.
6. Powers RWr, Kaeberlein M, Caldwell SD, Kennedy BK, Fields S. Extension of chronological life span in yeast by decreased TOR pathway signaling. Genes Dev. 2006; 20: 174-184.
7. Selman C, Lingard S, Choudhury AI, Batterham RL, Claret M, Clements M, Ramadani F, Okkenhaug K, Schuster E, Blanc E, Piper MD, Al-Qassab H, Speakman JR, Carmignac D, Robinson IC, Thornton JM, Gems D, Partridge L, Withers DJ. Evidence for lifespan extension and delayed age-related biomarkers in insulin receptor substrate 1 null mice. FASEB J. 2008; 22: 807-818.
8. Selman C, Tullet JM, Wieser D, Irvine E, Lingard SJ, Choudhury AI, Claret M, Al-Qassab H, Carmignac D, Ramadani F, Woods A, Robinson IC, Schuster E, Batterham RL, Kozma SC, Thomas G et al. Ribosomal protein S6 kinase 1 signaling regulates mammalian life span. Science. 2009; 326: 140-144.
9. Luong N, Davies CR, Wessells RJ, Graham SM, King MT, Veech R, Bodmer R, Oldham SM. Activated FOXO-mediated insulin resistance is blocked by reduction of TOR activity. Cell Metab. 2006; 4: 133-142.
10. Bjedov I, Partridge L. A longer and healthier life with TOR down-regulation: genetics and drugs. Biochem Soc Trans. 2011; 39: 460-465.
11. Katewa SD, Kapahi P. Role of TOR signaling in aging and related biological processes in Drosophila melanogaster. Exp Gerontol. 2011; 46: 382-390.
12. Stanfel MN, Shamieh LS, Kaeberlein M, Kennedy BK. The TOR pathway comes of age. Biochim Biophys Acta. 2009; 1790: 1067-1074.
13. Holzenberger M, Dupont J, Ducos B, Leneuve P, Geloen A, Even PC, Cervera P, Le Bouc Y. IGF-1 receptor regulates lifespan and resistance to oxidative stress in mice. Nature. 2003; 421: 182-187.
14. Partridge L, Alic N, Bjedov I, Piper MD. Ageing in Drosophila: the role of the insulin/Igf and TOR signalling network. Exp Gerontol. 2011; 46: 376-381.
15. Gems D, Partridge L. Genetics of Longevity in Model Organisms: Debates and Paradigm Shifts. Annu Rev Physiol. 2013; 75: 621-644.
16. Gems DH, de la Guardia YI. Alternative Perspectives on Aging in C. elegans: Reactive Oxygen Species or Hyperfunction? Antioxid Redox Signal. 2013; 19: 321-329.
17. Wu JJ, Liu J, Chen EB, Wang JJ, Cao L, Narayan N, Fergusson MM, Rovira, II, Allen M, Springer DA, Lago CU, Zhang S, Dubois W, Ward T, Decabo R, Gavrilova O et al. Increased Mammalian Lifespan and a Segmental and Tissue-Specific Slowing of Aging after Genetic Reduction of mTOR Expression. Cell Rep. 2013; 4: 913-920.
18. Leontieva OV, Novototskaya LR, Paszkiewicz GM, Komarova EA, Gudkov AV, Blagosklonny MV. Dysregulation of the mTOR pathway in p53-deficient mice. Cancer Biol Ther. 2013; 14:1182-1188.
19. Ayyadevara S, Alla R, Thaden JJ, Shmookler Reis RJ. Remarkable longevity and stress resistance of nematode PI3K-null mutants. Aging Cell. 2008; 7: 13-22.
20. Khapre RV, Kondratova AA, Patel S, Dubrovsky Y, Wrobel M, Antoch MP, Kondratov RV. BMAL1-dependent regulation of the mTOR signaling pathway delays aging. Aging (Albany NY). 2014; 6: 48-57.
21. Robida-Stubbs S, Glover-Cutter K, Lamming DW, Mizunuma M, Narasimhan SD, Neumann-Haefelin E, Sabatini DM, Blackwell TK. TOR signaling and rapamycin influence longevity by regulating SKN-1/Nrf and DAF-16/FoxO. Cell Metab. 2012; 15: 713-724.
22. Blagosklonny MV. Aging and immortality: quasi-programmed senescence and its pharmacologic inhibition. Cell Cycle. 2006; 5: 2087-2102.
23. Blagosklonny MV. An anti-aging drug today: from senescence-promoting genes to anti-aging pill. Drug Disc Today. 2007; 12: 218-224.
24. Johnson SC, Rabinovitch PS, Kaeberlein M. mTOR is a key modulator of ageing and age-related disease. Nature. 2013; 493: 338-345.
25. Stipp D. A new path to longevity. Sci Am. 2012; 306: 32-39.
26. Blagosklonny MV, Hall MN. Growth and aging: a common molecular mechanism. Aging. 2009; 1: 357-362.
27. Campistol JM, Eris J, Oberbauer R, Friend P, Hutchison B, Morales JM, Claesson K, Stallone G, Russ G, Rostaing L, Kreis H, Burke JT, Brault Y, Scarola JA, Neylan JF. Sirolimus Therapy after Early Cyclosporine Withdrawal Reduces the Risk for Cancer in Adult Renal Transplantation. J Am Soc Nephrol. 2006; 17: 581-589.
28. Kauffman HM, Cherikh WS, Cheng Y, Hanto DW, Kahan BD. Maintenance immunosuppression with target-of-rapamycin inhibitors is associated with a reduced incidence of de novo malignancies. Transplantation. 2005; 80: 883-889.
29. Euvrard S, Morelon E, Rostaing L, Goffin E, Brocard A, Tromme I, Broeders N, del Marmol V, Chatelet V, Dompmartin A, Kessler M, Serra AL, Hofbauer GF, Pouteil-Noble C, Campistol JM, Kanitakis J et al. Sirolimus and secondary skin-cancer prevention in kidney transplantation. N Engl J Med. 2012; 367: 329-339.
30. Blagosklonny MV. Rapalogs in cancer prevention: Anti-aging or anticancer? Cancer Biol Ther. 2012; 13: 1349-1354.
31. Bravo-San Pedro JM, Senovilla L. Immunostimulatory activity of lifespan-extending agents. Aging (Albany NY). 2013; 5: 793-801.
32. Mannick JB, Del Giudice G, Lattanzi M, Valiante NM, Praestgaard J, Huang B, Lonetto MA, Maecker HT, Kovarik J, Carson S, Glass DJ, Klickstein LB. mTOR inhibition improves immune function in the elderly. Sci Transl Med. 6: 268ra179.
33. Kennedy B, Pennypacker JK. Aging intervantions get human. Oncotarget. 2015; 6: 590-591.
34. Diggle TA, Moule SK, Avison MB, Flynn A, Foulstone EJ, Proud CG, Denton RM. Both rapamycin-sensitive and -insensitive pathways are involved in the phosphorylation of the initiation factor-4E-binding protein (4E-BP1) in response to insulin in rat epididymal fat-cells. Biochem J. 1996; 316 ( Pt 2): 447-453.
35. Tuhackova Z, Sovova V, Sloncova E, Proud CG. Rapamycin-resistant phosphorylation of the initiation factor-4E-binding protein (4E-BP1) in v-SRC-transformed hamster fibroblasts. Int J Cancer. 1999; 81: 963-969.
36. Jiang YP, Ballou LM, Lin RZ. Rapamycin-insensitive regulation of 4e-BP1 in regenerating rat liver. J Biol Chem. 2001; 276: 10943-10951.
37. Choo AY, Yoon SO, Kim SG, Roux PP, Blenis J. Rapamycin differentially inhibits S6Ks and 4E-BP1 to mediate cell-type-specific repression of mRNA translation. Proc Natl Acad Sci U S A. 2008; 105: 17414-17419.
38. Choo AY, Blenis J. Not all substrates are treated equally: implications for mTOR, rapamycin-resistance and cancer therapy. Cell Cycle. 2009; 8: 567-572.
39. Benjamin D, Colombi M, Moroni C, Hall MN. Rapamycin passes the torch: a new generation of mTOR inhibitors. Nat Rev Drug Discov. 2011; 10: 868-880.
40. Hassan B, Akcakanat A, Sangai T, Evans KW, Adkins F, Eterovic AK, Zhao H, Chen K, Chen H, Do KA, Xie SM, Holder AM, Naing A, Mills GB, Meric-Bernstam F. Catalytic mTOR inhibitors can overcome intrinsic and acquired resistance to allosteric mTOR inhibitors. Oncotarget. 2014; 5: 8544-8557.
41. Kang SA, Pacold ME, Cervantes CL, Lim D, Lou HJ, Ottina K, Gray NS, Turk BE, Yaffe MB, Sabatini DM. mTORC1 phosphorylation sites encode their sensitivity to starvation and rapamycin. Science. 2013; 341: 1236566.
42. Thoreen CC, Kang SA, Chang JW, Liu Q, Zhang J, Gao Y, Reichling LJ, Sim T, Sabatini DM, Gray NS. An ATP-competitive mammalian target of rapamycin inhibitor reveals rapamycin-resistant functions of mTORC1. J Biol Chem. 2009; 284: 8023-8032.
43. Yellen P, Saqcena M, Salloum D, Feng J, Preda A, Xu L, Rodrik-Outmezguine V, Foster DA. High-dose rapamycin induces apoptosis in human cancer cells by dissociating mTOR complex 1 and suppressing phosphorylation of 4E-BP1. Cell Cycle. 2011; 10: 3948-3956.
44. Liu Y, Vertommen D, Rider MH, Lai YC. Mammalian target of rapamycin-independent S6K1 and 4E-BP1 phosphorylation during contraction in rat skeletal muscle. Cell Signal. 2013; 25: 1877-1886.
45. Markman B, Dienstmann R, Tabernero J. Targeting the PI3K/Akt/mTOR pathway--beyond rapalogs. Oncotarget. 2010; 1: 530-543.
46. Chresta CM, Davies BR, Hickson I, Harding T, Cosulich S, Critchlow SE, Vincent JP, Ellston R, Jones D, Sini P, James D, Howard Z, Dudley P, Hughes G, Smith L, Maguire S et al. AZD8055 is a potent, selective, and orally bioavailable ATP-competitive mammalian target of rapamycin kinase inhibitor with in vitro and in vivo antitumor activity. Cancer Res. 2010; 70: 288-298.
47. Guo Y, Kwiatkowski DJ. Equivalent benefit of rapamycin and a potent mTOR ATP-competitive inhibitor, MLN0128 (INK128), in a mouse model of tuberous sclerosis. Mol Cancer Res. 2013; 11: 467-473.
48. Yu K, Toral-Barza L, Shi C, Zhang WG, Lucas J, Shor B, Kim J, Verheijen J, Curran K, Malwitz DJ, Cole DC, Ellingboe J, Ayral-Kaloustian S, Mansour TS, Gibbons JJ, Abraham RT et al. Biochemical, cellular, and in vivo activity of novel ATP-competitive and selective inhibitors of the mammalian target of rapamycin. Cancer Res. 2009; 69: 6232-6240.
49. Blagosklonny MV. Cell senescence and hypermitogenic arrest. EMBO Rep. 2003; 4: 358-362.
50. Blagosklonny MV. Geroconversion: irreversible step to cellular senescence. Cell Cycle. 2014: 2014;13:3628-2635
51. Blagosklonny MV. Cell cycle arrest is not yet senescence, which is not just cell cycle arrest: terminology for TOR-driven aging. Aging (Albany NY). 2012; 4: 159-165.
52. Sousa-Victor P, Gutarra S, Garcia-Prat L, Rodriguez-Ubreva J, Ortet L, Ruiz-Bonilla V, Jardi M, Ballestar E, Gonzalez S, Serrano AL, Perdiguero E, Munoz-Canoves P. Geriatric muscle stem cells switch reversible quiescence into senescence. Nature. 2014; 506: 316-321.
53. Sousa-Victor P, Perdiguero E, Munoz-Canoves P. Geroconversion of aged muscle stem cells under regenerative pressure. Cell Cycle. 2014; 13: 3183-3190.
54. Demidenko ZN, Blagosklonny MV. Growth stimulation leads to cellular senescence when the cell cycle is blocked. Cell Cycle. 2008; 7: 3355-3361.
55. Demidenko ZN, Zubova SG, Bukreeva EI, Pospelov VA, Pospelova TV, Blagosklonny MV. Rapamycin decelerates cellular senescence. Cell Cycle. 2009; 8: 1888-1895.
56. Demidenko ZN, Korotchkina LG, Gudkov AV, Blagosklonny MV. Paradoxical suppression of cellular senescence by p53. Proc Natl Acad Sci U S A. 2010; 107: 9660-9664.
57. Leontieva OV, Natarajan V, Demidenko ZN, Burdelya LG, Gudkov AV, Blagosklonny MV. Hypoxia suppresses conversion from proliferative arrest to cellular senescence. Proc Natl Acad Sci U S A. 2012; 109: 13314-13318.
58. Leontieva OV, Demidenko ZN, Blagosklonny MV. Contact inhibition and high cell density deactivate the mammalian target of rapamycin pathway, thus suppressing the senescence program. Proc Natl Acad Sci U S A. 2014; 111: 8832-8837.
59. Korotchkina LG, Leontieva OV, Bukreeva EI, Demidenko ZN, Gudkov AV, Blagosklonny MV. The choice between p53-induced senescence and quiescence is determined in part by the mTOR pathway. Aging (Albany NY). 2010; 2: 344-352.
60. Leontieva OV, Blagosklonny MV. DNA damaging agents and p53 do not cause senescence in quiescent cells, while consecutive re-activation of mTOR is associated with conversion to senescence. Aging (Albany NY). 2010; 2: 924-935.
61. Leontieva OV, Demidenko ZN, Blagosklonny MV. S6K in geroconversion. Cell Cycle. 2013; 12: 3249-3252.
62. Leontieva OV, Blagosklonny MV. CDK4/6-inhibiting drug substitutes for p21 and p16 in senescence: duration of cell cycle arrest and MTOR activity determine geroconversion. Cell Cycle. 2013; 12: 3063-3069.
63. Leontieva OV, Lenzo F, Demidenko ZN, Blagosklonny MV. Hyper-mitogenic drive coexists with mitotic incompetence in senescent cells. Cell Cycle. 2012; 11: 4642 - 4649.
64. Leontieva OV, Demidenko ZN, Blagosklonny MV. MEK drives cyclin D1 hyperelevation during geroconversion. Cell Deth Diff. 2013; 20: 1241-1249.
65. Pospelova TV, Leontieva OV, Bykova TV, Zubova SG, Pospelov VA, Blagosklonny MV. Suppression of replicative senescence by rapamycin in rodent embryonic cells. Cell Cycle. 2012; 11: 2402-2407.
66. Pospelova TV, Demidenko ZN, Bukreeva EI, Pospelov VA, Gudkov AV, Blagosklonny MV. Pseudo-DNA damage response in senescent cells. Cell Cycle. 2009; 8: 4112-4118.
67. Kolesnichenko M, Hong L, Liao R, Vogt PK, Sun P. Attenuation of TORC1 signaling delays replicative and oncogenic RAS-induced senescence. Cell Cycle. 2012; 11: 2391-2401.
68. Halicka HD, Zhao H, Li J, Lee YS, Hsieh TC, Wu JM, Darzynkiewicz Z. Potential anti-aging agents suppress the level of constitutive mTOR- and DNA damage- signaling. Aging (Albany NY). 2012; 4: 952-965.
69. Hinojosa CA, Mgbemena V, Van Roekel S, Austad SN, Miller RA, Bose S, Orihuela CJ. Enteric-delivered rapamycin enhances resistance of aged mice to pneumococcal pneumonia through reduced cellular senescence. Exp Gerontol. 2012; 47: 958-965.
70. Cho S, Hwang ES. Status of mTOR activity may phenotypically differentiate senescence and quiescence. Mol Cells. 2012; 33: 597-604.
71. Serrano M. Dissecting the role of mTOR complexes in cellular senescence. Cell Cycle. 2012; 11: 2231-2232.
72. Dulic V. Senescence regulation by mTOR. Methods Mol Biol. 2013; 965: 15-35.
73. Iglesias-Bartolome R, Patel V, Cotrim A, Leelahavanichkul K, Molinolo AA, Mitchell JB, Gutkind JS. mTOR inhibition prevents epithelial stem cell senescence and protects from radiation-induced mucositis. Cell Stem Cell. 2012; 11: 401-414.
74. Luo Y, Li L, Zou P, Wang J, Shao L, Zhou D, Liu L. Rapamycin enhances long-term hematopoietic reconstitution of ex vivo expanded mouse hematopoietic stem cells by inhibiting senescence. Transplantation. 2014; 97: 20-29.
75. Luo LL, Xu JJ, Fu YC. Rapamycin prolongs female reproductive lifespan. Cell Cycle. 2013; 12: 3353-3354.
76. Avolio E, Gianfranceschi G, Cesselli D, Caragnano A, Athanasakis E, Katare R, Meloni M, Palma A, Barchiesi A, Vascotto C, Toffoletto B, Mazzega E, Finato N, Aresu G, Livi U, Emanueli C et al. Ex vivo molecular rejuvenation improves the therapeutic activity of senescent human cardiac stem cells in a mouse model of myocardial infarction. Stem Cells. 2014; 32: 2373-2385.
77. Zhao H, Halicka HD, Li J, Darzynkiewicz Z. Berberine suppresses gero-conversion from cell cycle arrest to senescence. Aging (Albany NY). 2013; 5: 623-636.
78. Cao K, Graziotto JJ, Blair CD, Mazzulli JR, Erdos MR, Krainc D, Collins FS. Rapamycin reverses cellular phenotypes and enhances mutant protein clearance in Hutchinson-Gilford progeria syndrome cells. Sci Transl Med. 2011; 3: 89ra58.
79. Mercier I, Camacho J, Titchen K, Gonzales DM, Quann K, Bryant KG, Molchansky A, Milliman JN, Whitaker-Menezes D, Sotgia F, Jasmin JF, Schwarting R, Pestell RG, Blagosklonny MV, Lisanti MP. Caveolin-1 and accelerated host aging in the breast tumor microenvironment: chemoprevention with rapamycin, an mTOR inhibitor and anti-aging drug. Am J Pathol. 2012; 181: 278-293.
80. Chang BD, Broude EV, Fang J, Kalinichenko TV, Abdryashitov R, Poole JC, Roninson IB. p21Waf1/Cip1/Sdi1-induced growth arrest is associated with depletion of mitosis-control proteins and leads to abnormal mitosis and endoreduplication in recovering cells. Oncogene. 2000; 19: 2165-2170.
81. Demidenko ZN, Blagosklonny MV. Quantifying pharmacologic suppression of cellular senescence: prevention of cellular hypertrophy versus preservation of proliferative potential. Aging (Albany NY). 2009; 1: 1008-1016.
82. Leontieva OV, Blagosklonny MV. Tumor promoter-induced cellular senescence: cell cycle arrest followed by geroconversion. Oncotarget. 2014; 5: 12715-12727.
83. Blagosklonny MV. Rapamycin and quasi-programmed aging: Four years later. Cell Cycle. 2010; 9: 1859-1862.
84. Blagosklonny MV. Rejuvenating immunity: “anti-aging drug today” eight years later. Oncotarget. 2015; in press
85. Harrison DE, Strong R, Sharp ZD, Nelson JF, Astle CM, Flurkey K, Nadon NL, Wilkinson JE, Frenkel K, Carter CS, Pahor M, Javors MA, Fernandezr E, Miller RA. Rapamycin fed late in life extends lifespan in genetically heterogenous mice. Nature. 2009; 460: 392-396.
86. Anisimov VN, Zabezhinski MA, Popovich IG, Piskunova TS, Semenchenko AV, Tyndyk ML, Yurova MN, Antoch MP, Blagosklonny MV. Rapamycin extends maximal lifespan in cancer-prone mice. Am J Pathol. 2010; 176: 2092-2097.
87. Anisimov VN, Zabezhinski MA, Popovich IG, Piskunova TS, Semenchenko AV, Tyndyk ML, Yurova MN, Rosenfeld SV, Blagosklonny MV. Rapamycin increases lifespan and inhibits spontaneous tumorigenesis in inbred female mice. Cell Cycle. 2011; 10: 4230-4236.
88. Wilkinson JE, Burmeister L, Brooks SV, Chan CC, Friedline S, Harrison DE, Hejtmancik JF, Nadon N, Strong R, Wood LK, Woodward MA, Miller RA. Rapamycin slows aging in mice. Aging Cell. 2012; 11: 675-682.
89. Comas M, Toshkov I, Kuropatwinski KK, Chernova OB, Polinsky A, Blagosklonny MV, Gudkov AV, Antoch MP. New nanoformulation of rapamycin Rapatar extends lifespan in homozygous p53-/- mice by delaying carcinogenesis. Aging (Albany NY). 2012; 4: 715-722.
90. Komarova EA, Antoch MP, Novototskaya LR, Chernova OB, Paszkiewicz G, Leontieva OV, Blagosklonny MV, Gudkov AV. Rapamycin extends lifespan and delays tumorigenesis in heterozygous p53+/- mice. Aging (Albany NY). 2012; 4: 709-714.
91. Ramos FJ, Chen SC, Garelick MG, Dai DF, Liao CY, Schreiber KH, MacKay VL, An EH, Strong R, Ladiges WC, Rabinovitch PS, Kaeberlein M, Kennedy BK. Rapamycin reverses elevated mTORC1 signaling in lamin A/C-deficient mice, rescues cardiac and skeletal muscle function, and extends survival. Sci Transl Med. 2012; 4: 144ra103.
92. Livi CB, Hardman RL, Christy BA, Dodds SG, Jones D, Williams C, Strong R, Bokov A, Javors MA, Ikeno Y, Hubbard G, Hasty P, Sharp ZD. Rapamycin extends life span of Rb1+/- mice by inhibiting neuroendocrine tumors. Aging (Albany NY). 2013; 5: 100-110.
93. Miller RA, Harrison DE, Astle CM, Fernandez E, Flurkey K, Han M, Javors MA, Li X, Nadon NL, Nelson JF, Pletcher S, Salmon AB, Sharp ZD, Van Roekel S, Winkleman L, Strong R. Rapamycin-mediated lifespan increase in mice is dose and sex dependent and metabolically distinct from dietary restriction. Aging Cell. 2014; 13:468-477
94. Popovich IG, Anisimov VN, Zabezhinski MA, Semenchenko AV, Tyndyk ML, Yurova MN, Blagosklonny MV. Lifespan extension and cancer prevention in HER-2/neu transgenic mice treated with low intermittent doses of rapamycin. Cancer Biol Ther. 2014; 15: 586-592.
95. Zhang Y, Bokov A, Gelfond J, Soto V, Ikeno Y, Hubbard G, Diaz V, Sloane L, Maslin K, Treaster S, Rendon S, van Remmen H, Ward W, Javors M, Richardson A, Austad SN et al. Rapamycin extends life and health in C57BL/6 mice. J Gerontol A Biol Sci Med Sci. 2014; 69: 119-130.
96. Fok WC, Chen Y, Bokov A, Zhang Y, Salmon AB, Diaz V, Javors M, Wood WH, 3rd, Becker KG, Perez VI, Richardson A. Mice fed rapamycin have an increase in lifespan associated with major changes in the liver transcriptome. PLoS One. 2013; 9: e83988.
97. Leontieva OV, Paszkiewicz GM, Blagosklonny MV. Weekly administration of rapamycin improves survival and biomarkers in obese male mice on high-fat diet. Aging Cell. 2014; 13: 616-622.
98. Hasty P, Livi CB, Dodds SG, Jones D, Strong R, Javors M, Fischer KE, Sloane L, Murthy K, Hubbard G, Sun L, Hurez V, Curiel TJ, Sharp ZD. eRapa Restores a Normal Life Span in a FAP Mouse Model. Cancer Prev Res (Phila). 2014; 7: 169-178.
99. Fischer KE, Gelfond JA, Soto VY, Han C, Someya S, Richardson A, Austad SN. Health Effects of Long-Term Rapamycin Treatment: The Impact on Mouse Health of Enteric Rapamycin Treatment from Four Months of Age throughout Life. PLoS One. 10: e0126644.
100. Ye L, Widlund AL, Sims CA, Lamming DW, Guan Y, Davis JG, Sabatini DM, Harrison DE, Vang O, Baur JA. Rapamycin doses sufficient to extend lifespan do not compromise muscle mitochondrial content or endurance. Aging (Albany NY). 2013; 5: 539-550.
101. Johnson SC, Yanos ME, Kayser EB, Quintana A, Sangesland M, Castanza A, Uhde L, Hui J, Wall VZ, Gagnidze A, Oh K, Wasko BM, Ramos FJ, Palmiter RD, Rabinovitch PS, Morgan PG et al. mTOR inhibition alleviates mitochondrial disease in a mouse model of Leigh syndrome. Science. 2013; 342: 1524-1528.
102. Fang Y, Bartke A. Prolonged rapamycin treatment led to beneficial metabolic switch. Aging (Albany NY). 2013; 5: 328-329.
103. Spong A, Bartke A. Rapamycin slows aging in mice. Cell Cycle. 2012; 11: 845.
104. Blagosklonny MV. Rapamycin extends life- and health span because it slows aging. Aging (Albany NY). 2013; 5: 592-598.
105. Blagosklonny MV. Prospective treatment of age-related diseases by slowing down aging. Am J Pathol. 2012; 181: 1142-1146.
106. Blagosklonny MV. TOR-centric view on insulin resistance and diabetic complications: perspective for endocrinologists and gerontologists. Cell Death Dis. 2013; 4: e964.
107. Blagosklonny MV. Answering the ultimate question “what is the proximal cause of aging?” Aging (Albany NY). 2012; 4: 861-877.
108. Blagosklonny MV. How to save Medicare: the anti-aging remedy. Aging (Albany NY). 2012; 4: 547-552.
109. Blagosklonny MV. Selective anti-cancer agents as anti-aging drugs. Cancer Biol Ther. 2013; 14: 1092-7.
110. Blagosklonny MV. Immunosuppressants in cancer prevention and therapy. Oncoimmunology. 2013; 2: e26961.
111. Leontieva O, Gudkov A, Blagosklonny M. Weak p53 permits senescence during cell cycle arrest. Cell Cycle. 2010; 9: 4323-4327.